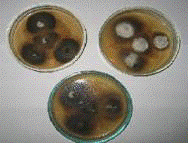

Жовто-бура плямистість пшениці – Pyrenophora - tritici repentis
СЕЛЕКЦІЙНО-ГЕНЕТИЧНИЙ
ІНСТИТУТ - НАЦІОНАЛЬНИЙ ЦЕНТР НАСІННЕЗНАВСТВА ТА СОРТОВИВЧЕННЯ
РЕФЕРАТ
ДЛЯ
СКЛАДАННЯ КАНДИДАТСЬКОГО ІСПИТУ ЗІ СПЕЦІАЛЬНОСТІ ФІТОПАТОЛОГІЯ
Жовто-бура
плямистість пшениці - Pyrenophora
- tritici repentis
Виконавець:
Одностальченко
Катерина Вікторівна
Одеса-2012
Зміст
Вступ
1.
Плямистості грибної етіології
.1 Жовта плямистість -
піренофороз (Pyrenophora tritici-repеntis). Симптоми ураження
1.2 Життєвий цикл гриба
.3 Морфологічні та культуральні
властивості патогена
.4 Система диференціації рас
Pyrenophora tritici-repеntis з використанням хозяїноспецифічних токсинів
.5 Виділення гриба в чисту
культуру і напрацювання інокулюма
.6 Інокуляція
.7 Методи оцінки стійкості
Висновок
Список використаних джерел
Вступ
Пшениця - важлива зернова
продовольча культура, яка за посівними площами займає перше місце у світі. В
Україні озима пшениця традиційно є головною зерновою культурою, посіви якої
займають, залежно від року, 6,4-7,3 млн. га землі. В умовах інтенсивного
сільськогосподарського виробництва шкідливі організми - збудники хвороб,
шкідники та бур’яни - це частіше за все головні фактори, що обмежують зростання
валових зборів продукції.
У світі від шкідників і збудників
хвороб втрати врожаю пшениці щорічно становлять у середньому 14,1% [1]. У роки
потужних епіфітотій та масового розмноження шкідників ці показники значно
зростають. В Україні врожай пшениці з кожного четвертого засіяного хліборобом
гектара землі «з’їдається» збудниками захворювань і шкідниками. Серед збудників
хвороб левова частка приходиться на гриби-мікроміцети [1]. Врожайність пшениці
і її стабільність визначаються безліччю ознак і властивостей, серед яких
найважливіше значення має тривалість функціонування листового апарату.
Безпосереднє погіршення діяльності фотосинтетичного апарату спричинюють
хвороби, особливо листяної етіології.
У Степу України на пшениці
плямистості листя, спричинені некротрофними патогенами - явище розповсюджене.
Окрім традиційної вже септоріозної плямистості все частіше спостерігаються
також жовта плямистість - піренофороз, темно - бура - кохліобольоз, на твердій
пшениці - сколекотріхоз. Плямистості, спричинені аскохітою, фузаріями,
альтернарією, ризоктонією - зустрічаються подекуди, але економічно значимої
шкоди не завдають. Жовта плямистість (піренофороз) серед хвороб листя в Україні
зайняла лідируюче положення не так давно. У зоні Степу України вперше
науковцями відділу фітопатології та ентомології було діагностовано патоген,
збудник цієї хвороби у 1996 р. Частота, з якою зустрічався патоген, поступалася
видам септорії, сколекотриху. Однак, вже через 7-8 років піренофороз став
однією з головних проблем для вирощування озимої пшениці. Масові ураження
збудником розпочалися з весни 2006р, а епіфітотія захворювання сталася навесні
2007 р. З цього часу піренофороз впевнено посів чільне місце серед усіх
плямистостей. Нашими дослідженнями встановлено, що жовта плямистість може
розвиватися у декількох напрямках - з формуванням некротичних плям, або ж
хлоротичних. Можливий змішаний характер хвороби. У Селекційно-генетичному
інституті дослідження щодо ідентифікації рас Pyrenophora
tritici-repentis
розпочаті у 2007 році. За попередніми результатами визначили, що в популяції
патогену присутні раси 1 та 2. Наразі Pyrenophora
tritici-repentis
займає друге положення серед збудників листових плямистостей, поступаючись
септорії. За останніми відомостями і за нашими дослідженнями встановлено, що
від цієї хвороби втрачається від 20 до 70% врожаю. Необхідною умовою для
розв'язання проблеми стійкості проти фітопатогенів є пошук нового вихідного
матеріалу.
Патосистема РTR пшениці
характеризується диференціальною взаємодією генотипів рослин та патогену.
пшениця плямистість листя
гриб
1. Плямистості листя грибної
етіології
У Степовій частині України складаються
найсприятливіші погодні умови для поширення і розвитку фітопатогенних об'єктів
- це збудники хвороб, які в окремі роки істотно знижують урожай і його якість.
До числа найбільш поширених хвороб озимих колосових культур можна віднести
борошнисту росу, буру іржу, фузаріозну та гельмінтоспоріозну кореневі гнилі,
тверду сажку, фузаріоз і альтернаріоз колосу й зерна, септоріозну некротичну
плямистість листя і септоріоз колосу, бактеріальні та вірусні інфекції [2].
Моніторингом останніх років
встановлено домінування на озимій пшениці та ячменю плямистостей різної
етиології. Окрім септоріозної плямистості спостерігаються також жовта
плямистість - піренофороз, темно - бура - кохліобольоз, на твердій пшениці -
сколекотріхоз. Щорічно ці захворювання заражають площі посівів пшениці з
поширенням 48-62%. Аскохітозна, фузаріозна, альтернаріозна, ризоктоніоз на
плямистості зустрічаються нечасто і економічно значимої шкоди не завдають
[1].
.1 Жовта плямистість - піренофороз
(Pyrenophora tritici-repеntis). Симптоми ураження.
Збудник захворювання - гомоталічний
аскоміцет Pyrenophora tritici-repеntis (Died.) Drechsler (син. Pyrenophora
frichostoma (Fr.); недосконала стадія Drechslera tritici-repentis (Died)
Shoemaker; Helminthosporium tritici-repentis Died.). Належить до відділу
Ascomycota, класу Dothideomycetes, підкласу Pleosporomycetidae, порядку
Pleosporales, родини Pleosporaceae, роду Pyrenophora, виду Pyrenophora
tritici-repеntis [3].
Жовта плямистість серед листкових
хвороб пшениці зайняла домінуюче положення в усіх основних зонах вирощування
пшениці - у Канаді [2-3], США, Південній Америці, Південній Африці, Індії,
Австралії [2].

Рисунок 1. Жовта плямистість -
піренофороз (оригінал): а - уражене листя; б - конідії.
Макмюлен встановив, що піренофора
відноситься до найбільш економічно небезпечних хвороб пшениці в Північній
Дакоті, в США [11].
Анноне відмітив, що в Аргентині
ураження піренофорою може розвиватися до 50%, а втрати урожаю сягають від 10 до
20 % [1].
За повідомленням Кохлі [4]
шкідливість P. tritici-repentis збільшується з підвищенням застосування
нульового обробітку ґрунту у землеробстві, особливо у Бразилії і Парагваї, де
використання нульового обробітку з 50 000 га у 1975 р. зросло до 350 000 га у
1990 р.
На території СНД піренофороз
спостерігається у Білорусі, Росії, країнах Балтії, Середньої Азії, Молдові
[5,6]. У Росії хвороба найбільш шкідлива на Північному Кавказі. Тут вона вперше
була зареєстрована у 1985 р. Хвороба призводить до значної шкоди також на
Алтаї, у Башкирії, Ленінградській, Псковській, Новгородській областях [7].
Карта поширення Pyrenophora
tritici-repеntis на пшениці та дикорослих злаках
[3]

Рисунок 2
Крім пшениці, також уражує більше 62
видів злаків із роду Agropyron,
Agrostis, Alopecurus,
Aegilops, Avena,
Androgon, Bromus,
Hordeum, Lollium,
Festuca, Setaria,
Sorghum та інші.
Симптоми захворювання проявляються на 3-7 добу після ураження. Хвороба
проявляється на обох сторонах листя у вигляді хлоротичних жовтувато-коричневих,
темно-коричневих плям овальної форми і різного розміру. На листках стійких
сортів вони дрібні, до 0,5 мм, сприйнятливих - 0,6-3,0 мм. На різних сортах
пшениці симптоми можуть варіювати; зона хлорозу може бути більшою, або взагалі
відсутньою. Наявність в центрі плями темно - коричневої цятки придає йому вид
ока. При розростанні плями зливаються. Інфіковані листя по мірі збільшення зони
ураження відмирають, починаючи з верхівки листка. Некротичні плями складаються
з жовто-коричневої, коллапсованої тканини, в той час як хлоротичні плями
являються результатом поступового пожовтіння тканини, спочатку без її коллапсу [8].
Гриб крім листя, уражує стебло,
колоскові луски та піхви рослини. На стеблах пшениці утворюються сіро-коричневі
та темно - бурі смужки приблизно 10 х 4 мм із хлоротичною облямівкою. На лусках
колоса патоген викликає видовженно - штрихоподібні плями бурого кольору [9].
Окрім звичайної плямистості листя Pyrenophora tritici-repеntis викликає симптом
«чорний зародок», рожевість насіння та буру плямистість лусок і остей колосся.
Симптоми хвороби зрідка проявляються на зерні у вигляді побуріння у зоні
зародка.
Симптоми, які проявляються на
листках, схожі на симптоми Septoria nodorum. У посушливі роки у деяких сортів
пшениці також виявляються схожі на ураження Drechslera tritici-repentis плями,
що спричинені виключно недоліком вологи. Враження листових пазух вказує швидше
на присутність Septoria nodorum, але з впевненістю про це можна судити лише за
мікроскопіювання органів розмноження, як мінімум, за 30-разового збільшення.
Конідієносці Drechslera tritici-repentis розташовані на поверхні листа окремо.
Конідієносці клядоспорія (Cladosporium spp.)
рунисті, тонші і менші. На стадії дозрівання зерна з'являються розташовані
окремо конідієносці Alternaria, але в порівнянні з конідієносцями Drechslera
tritici-repentis вони тонші і менші, характеризуються довгими загостреними
вгорі кінцями і з'єднані в ланцюжки (схожі на зміїну голову).
.2 Життєвий цикл гриба
Збудник жовтої плямистості має
сумчасту та конідіальну стадію розвитку. Гриб паразитує в конідіальній стадіїї;
сумчаста стадія розвивається на відмерлих рештках тканин і слугує для
перезимівлі. Плодові тіла - псевдотеції закладаються восени на ураженій соломі
у вигляді мілких, чорних, округлих утворень, які припіднімаються над поверхнею
стебла. Восени на стеблах і піхвах листя утворює дрібні, чорні плодові тіла -
перитеції з асками, в яких розвиваються 8 аскоспор. Останні овальної форми,
коричневі, розміром 18-20 х 45-70 мкм з трьома поперечними й однією поздовжньою
перетинками [10].
Навесні під час випадання дощів та
повітряних течій зрілі аскоспори через верхній отвір перитецію під тиском
викидаються назовні. Вони є первинним інокулюмом для зараження рослин. Під час
вегетації рослин на поверхні листка через продихи або між клітинами епідермісу
з’являються одноклітинні конідієносці з поодинокими прямими або злегка
зігнутими циліндричними із закругленою верхівкою, що схожа на голову змії,
поперечними перетинками конідії. Вони безбарвні або солом’яного кольору,
гладенькі, є вторинним інокулюмом. Вітровим потоком переносяться приблизно на
75 м.

Рисунок 3
.3 Морфологічні та культуральні
властивості патогенна
Одним із основних діагностичних
ознак Pyrenophora tritici-repеntis є форма базальної клітини конідії, яка
описується, як «зміїна голова» [6]. Конідії поодинокі, прямі або злегка
зігнуті, циліндричні, з закругленими кінцями від прозорих до жовто-бурих, з 1-9
(частіше з 4-7) дистосептами. Розміри у різних ізолятів і на різних середовищах
можуть коливатися від 40-245х10-20 мкм [11].
Конідієносці поодинокі, прямі або звивисті, інколи колінчасто-звивисті, часто з
роздутою основою, циліндричні або злегка звужені в вершині, приблизно 400 мкм
довжиною, 6-12 мкм шириною, діаметром - 8-9 мкм, з декількома слабко вираженими
сегментами.
Плодові тіла - псевдотеції закладаються
восени на ураженій соломі. В зрілому стані вони представляють собою округлі
чорні випуклі утворення. При дозріванні виступають над субстратом завдяки
шийці, яка покрита ворсинками. Діаметр перитеціїв сягає 200-500 мкм. Всередині
плодового тіла аски розміщені пучком, в кожній по 8 аскоспор, розділених трьома
поперечними та 1-2 продовжніми перетинками на рівні центральних клітин.
Аскоспори овальні, розміром 180-290х24-60 мкм, від прозорих до жовто - бурих з
закругленими кінцями[12].
Рисунок 4
В культурі гриб Pyrenophora
tritici-repеntis добре розвивається на штучних середовищах КГА, V4,
морковному агарі. На цих середовищах гриб продукує сірий або світло - сірий
міцелій, часто з окремими частинками білого, пухкого, стерильного міцелію.
Строма зафарбована від сірого до темно - оливкового кольору, деякі ізоляти
виділяють від рожевого до цегляно - червоного пігменту. Утворення конідіофорів
гриба стимулює інтенсивне освітлення: ультрафіолетова частина спектру, тому використовують
бактерицидні лампи ЛВ - 40.
.4 Система диференціації рас
Pyrenophora tritici-repеntis з використанням хозяїноспецифічних токсинів
Відомо два симптоми, пов’язаних з
жовтою плямистістю: некроз та хлороз. В результаті специфічної взаємодії між рослиною-живителем
і патогеном було показано, що індивідуальні ізоляти гриба можуть викликати на
специфічних лініях і сортах пшениці різні симптоми, незалежно від їх генотипів
[13].
Штами першого патотипу утворюють
некроз і хлороз (nec + chl +), другого патотипу - тільки некроз (nec + chl -),
третього патотипу - хлороз (nec - chl +), четвертого патотипу не утворюють ні
хлорозів, ні некрозів (nec - chl -). Специфічність взаємодії ізолятів гриба з
рослиною обумовлена наявністю відомих на даний момент трьох хозяїно -
специфічних токсинів - Ptr
ToxA, Ptr
ToxB та Ptr
ToxC [14]. Токсин Ptr
ToxA відповідає за розвиток некрозу в тканинах сприйнятливих ліній та сортів. В
його основу входить рибосомальний синтетичній білок з молекулярною вагою 13,2 кDa,
що відрізняє його від більшості грибних токсинів. Ptr
ToxB індукує утворення хлорозу внаслідок інгібірування фотосинтезу. Він є
низькомолекулярним білком з масою 6,6 кDa.
Третій токсин Ptr
ToxC - низькомолекулярний, хозяїноспецифічний не білкової природи, також
викликає утворення хлорозу, але на других сортах пшениці відносно токсину Ptr
ToxB. Штам гриба може продукувати один, два або три токсини [15].
Залежно від цього на пшениці можуть спостерігатися різні симптоми хвороби. За
поєднання симптомів штами можуть бути віднесені до наступних чотирьох
патотипів. На основі цих даних розроблена система диференціації рас патогена.
Перші дослідження расового складу
збудника жовтої плямистості листя пшениці виконані в Канаді фітопатологом
Ламарі з колегами в 1990-1994 р. [9].
За допомогою сортів-диференціаторів Glenlea, GB662 і GB365 ідентифіковані
чотири раси, з яких раса 1 продукує токсин PtrToxA і PtrToxC, раса 2 - PtrToxA,
раса 3 - PtrToxC, раса 4, не утворює токсинів. Трохи пізніше ці дослідники
визначили расовий склад патогена на території країн, розташованих на Великому
Шовковому шляху - у Казахстані, Киргизстані, Узбекистані, Азербайджані, Сирії
[9]. У популяціях на території Азербайджану і Сирії виявлені раси 1, 2, 3, 5, 7
і 8, тоді як у популяціях з Казахстану, Киргизстану й Узбекистану.
Таблиця 1. Характеристика рас
Pyrenophora tritici-repеntis по здатності утворювати екзотоксини [15].
|
Індикатор токсину
|
Раса
|
|
4
|
2
|
1
|
8
|
7
|
5
|
6
|
3
|
|
Glenlea
|
|
|
|
|
6B662
|
|
|
|
PtrToxB
|
|
|
6B365
|
|
|
PtrToxC
|
|
|
PtrToxC
|
|
Число
токсинів
|
0
|
1
|
2
|
3
|
2
|
1
|
2
|
1
|
У Західній Європі раси збудника
жовтої плямистості листя пшениці вперше ідентифіковані Саровою у Чехії в
2000-2003 р. У популяції патогена домінувала раса 1, також зустрічалися раси 2
і 4 і нові, відсутні в реєстрі рас [10].
У Росії расовий склад збудника
жовтої плямистості листя пшениці вперше вивчений Михайловою з колегами у
Всеросійському науково-дослідному інституті захисту рослин в 2005-2007 р. Ними
ідентифіковано 6 рас.
.5 Виділення гриба у чисту культуру
і напрацювання інокулюма
Робота по напрацюванню інокулюма
складається з декількох етапів, а саме: з уражених рослин пшениці виділення
інфекційного матеріалу, зібраних на полях при маршрутних обстеженнях посівів в
Степовій зоні України; інокулюм напрацьовують на рідкому середовищі Солод-І наступного
складу: на 1 л готового середовища - солод 20г, глюкоза 10г, агар-агар - 0,5 г,
сік 10-денних проростків пшениці - 1 мл. Компоненти змішують в 1 л гарячої
дистильованої води, проціджують через подвійний шар марлі, потім розливають по
200 мл у колби Эрленмейера, стерилізували 40 хв. при 1,4-1,5 атм. В охолоджене
середовище висівали чисту культуру гриба з пробірки, витримували інкубацію
10-14 діб при 240С. Перед інокуляцією інокулюм розбавляли
дистильованою водою, доводячи концентрацію конідій до 107 мл. Для
більших обсягів оцінок в польовому інфекційному розсаднику інокулюм напрацьовують
на зерновому середовищі, краще на просі або сорго. Зерно попередньо відварюють
протягом 20 хв., після чого відціджують, змішують з 150 г крейди з розрахунку
на 10 кг зерна, розкладають у термостійкі поліпропіленові пакети по 1,2 кг у
кожний, закупорюють та стерилізують 1 годину 30 хв. при 1,8 атм. Через добу
пакети засівають рідким інокулюмом з розрахунку 20 мл на пакет, інкубацію
витримують 14-16 діб, після чого вміст кожного пакета висипають у миску,
заливають його 1 л дистильованої води, збивають інфекцію міксером, проціджують
через два шари марлі або спеціальні сита.
Шляхом
розведення дистильованою водою доводять концентрацію конідій у суспензії до 107/мл.
Перед інокуляцією в неї додають Твін 80 (0,002%)
[1].
.6 Інокуляція
Інокуляцію проводять навесні у
польових інфекційних розсадниках за оптимальної температурі повітря (табл. 1.)
і наявності вологи у вигляді роси або крапель дощу для проростання спор і
успішності зараження рослин. Відхилення від оптимальної температури в той чи
інший бік знижує інтенсивність проростання спор й успішність зараження.
Таблиця 2. Параметри температури для
проростання конідій Pyrenophora tritici-repentis і зараження рослин пшениці (0С)
|
Мінімум
|
Оптимум
|
Максимум
|
|
6-10
|
18-22
|
30
|
Інокуляцію проводять у фази «кінець
трубкування» - «прапорцевий лист» у вечірній час після заходу сонця та у
безвітряну погоду, під росу, що випадає, після дощу або поливу шляхом
обприскування рослин ранцевим обприскувачем з розрахунку витрати суспензії
250-300 мл на 1 м2 посіву. Якщо роса не очікується, то можна
інокульовані рослини ізолювати поліетиленовими пакетами для створення вологої
камери й успішності зараження. Наступного дня в сонячний ранок мішки необхідно
зняти до переходу температури повітря через 200С, щоб не допустити
опіків листя від сонячних променів. У похмуру погоду мішки залишають й знімають
наступного дня (Бабаянц
О.В., 2011р).
.7 Методи оцінки стійкості
Організація й проведення оцінок
стійкості пшениці до піренофори в умовах штучного клімату аналогічні оцінкам
стійкості до септорії.
У польовому інфекційному розсаднику
фітопатологічну оцінку стійкості рослин пшениці до збудника жовтої плямистості
проводять в декілька разів від початку формування зернівки до молочно-воскової
стиглості. Ступінь стійкості й сприйнятливості визначають за інтенсивністю
ураження прапорцевого й предпрапорцевого листка і типу реакції рослини на
інфекцію патогена. Інтенсивність ураження листка визначають окомірно в балах або
відсотках за шкалою, що на рисунку 1, а типи - по таблиці 2.
За показниками інтенсивності
ураження листя можна визначити площу під кривою розвитку хвороби.

Рис. 5. Шкала інтенсивності ураження
листя пшениці Pyrenophora tritici-repentis (Бабаянц О.В., 2011).
Таблиця 3. Шкала оцінок стійкості до
Pyrenophora tritici-repentis (Бабаянц О.В., 2011)
|
Бал
|
Тип реакції на інфекцію патогена
|
Характер прояву хвороби
|
Ступінь стійкості, сприйнятливості
|
|
1
|
2
|
3
|
4
|
|
9 8
|
0
|
Ознаки хвороби відсутні
|
Дуже висока і висока стійкість
|
|
VR
|
На листі дуже дрібні (до 0,5 мм)
темно-коричневі плями інтенсивністю до 5%, можливі дрібні, рідкі хлорозні
плями
|
|
|
7 6
|
R
|
На листі дрібні (до 1 мм) темно-коричневі
плями, можливо з хлорозом, інтенсивністю до 10%
|
Стійкість Помірна стійкість
|
|
MR
|
На листі дрібні (1-1,5 мм) темно-коричневі
плями, можливо з хлорозом, інтенсивністю до 15%
|
|
|
5
|
MS
|
На листі плями (до 2 мм) від світло-коричневих
до темно-коричневих з жовтим ореолом і жовтизною інтенсивністю до 25%
|
Слабка сприйнятливість
|
|
4
|
MS
|
На листі світло- і темно-коричневі плями (2-3
мм) з жовтизною інтенсивністю до 40%
|
Помірна Сприйнятливість
|
|
3
|
S
|
На листі світло-коричневі й темно-коричневі
плями (2-3 мм) з жовтизною інтенсивністю до 65%
|
Сприйнятливість
|
|
2 1
|
VS
|
На листі жовтизна й коричневі плями (2-3 мм)
інтенсивністю до 90%
|
|
VS
|
На листі жовтизна й коричневі плями (2-3 мм)
інтенсивністю 100%. Спостерігається загибель окремих ділянок листка (некроз)
або всього листка
|
|
Висновок
Серед листкових захворювань пшениці
як в світі, так і в Україні жовта плямистість листя пшениці, збудником якої є
аскоміцет Pуrenophora tritici-repentis (Died) Drechs., (анаморфа Drechslera
tritici-repentis (Died) стала відомою серед листкових захворювань порівняно
недавно. Перші повідомлення про виникнення епіфітотій жовтої плямистості
з'явилися в Австралії та Північній Америці в 70-х, а в Європі - у 80-х роках
20-го століття.
Сучасна система захисту
сільськогосподарських рослин від шкідливих об’єктів складається з комплексу
фітосанітарних заходів, які включають селекційно-генетичні, агротехнічні,
хімічні і біологічні. А для планування та успішної реалізації цих заходів вкрай
необхідними є знання про склад та стан популяцій шкідливих організмів, динаміку
та тенденції їх розвитку, потенційні втрати врожаю від них.
Тенденцією минулих років стало
загальне зменшення відсотку уражень посівів озимої пшениці бурою листковою
іржею і, разом з тим, збільшення плямистостей листя, спричинене, за нашими дослідженнями,
жовто-бурою плямистістю (піренофороз), септоріозом та фузаріозом [Бабаянц О.В.
2009р.].
Значно частіше, ніж в попередні роки
виявляли жовто-буру плямистість листя (Pirenophora
tritici-repentis),
яка була найбільш шкодо чинною і досягала розвитку на деяких сортах до 50 -70%.
Жовто-бура плямистість у світі зайняла домінуюче положення серед листових
хвороб пшениці порівняно недавно. Розповсюдження хвороби розвивається з великою
швидкістю, при цьому головну і найбільш суттєву роль в інтенсивності ураження
жовто-бурою плямистістю (піренофорозом) відіграє сорт, тобто рівень його
стійкості, сприйнятливості до патогену.
Для захисту від компонентів
патосистеми жовтої плямистості, необхідний підбір оптимальних сівообертів,
використання фунгіцидів і культивування стійких до хвороб сортів. Перші два
способи вважаються достатньо ефективними для зменшення кількості первинного
інокулюму. Використання стійких сортів забезпечує більш продовжене стримання
захворювання та безпечне для навколишнього середовища.
У технології вирощування пшениці
озимої, особливе місце належить генетичним факторам, які реалізуються через
такий засіб виробництва як сорт, який становить основу більшості технологій їх
вирощування. Формування врожайності пшениці озимої відбувається також і
внаслідок взаємодії її з умовами навколишнього природного середовища, які, в
свою чергу, створюються як об'єктивними факторами, до яких належать
ґрунтово-кліматичні умови, так і суб'єктивними, які виявляються у технології її
вирощування. Показано, що у різних географічних зонах, окремих регіонах вимоги
до стійких сортів пшениці озимої неоднакові, так як в одних умовах має велике
значення стійкість сорту до одного збудника, а в інших - до іншого, і при цьому
все залежить від умов, що сприяють розвиткові збудника тієї чи іншої хвороби,
яка є загрозою врожаю. Зважаючи на це, виведення сортів, що поєднують високий
потенціал урожайності з генетичним захистом його від лімітуючих чинників
середовища конкретних регіонів, шкідників і хвороб є однією з центральних ланок
в адаптивному землеробстві. Водночас, як частота, так й інтенсивність ураження
озимої пшениці хворобами обумовлюються не тільки кліматичними умовами певної
зони, але також залежать від рівня агротехнічних, організаційно-господарських
заходів і стійкості сортів пшениці, що вирощуються.
виникнення епіфітотій
жовтої плямистості
Список використаних джерел
1. Бабаянц О.В. Імунологічна
характеристика рослинних ресурсів пшениці та обгрунтуваня генетичного захисту
від збудників хвороб грибної етіології у Степу України. Дисетрація… д.б.н.,
Рукопис, 2011 р., 328 с.
. Андронова А.Є. Піренофороз
озимої пшениці в південно-західній частині Росії. / Захист і карантин рослин.
2001. N 5. C. 32.
. Михайлова Л.А., Пригоровський
Т.Г. Жовта плямистість листя пшениці. Pyrenophora tritici-repentis. / Мікологія
і фітопатологія. Т. 34. Вип. 1. С. 7-16.
. Kohli, M.M., Mehta, Y.R.
& de Ackermann, M.D. Spread of tan spot in the Southern cone region of
South America. / M.M. Kohli, Y.R. Mehta, & M.D. de Ackermann. In L.J.
Francl, J.M. Krupinsky & M.P McMullen, eds. Advances in Tan Spot Research
// Proc. 2nd Int. Tan Spot Workshop. 1992, - P. 86-90.
. Санін С.С., Черкашин В.І.,
Назарова Л.М., Соколова Є.А., Стріжекозін Ю.А., Ібрагімов Т.З., Неклеса М.П.
Фітосанітарна експертиза зернових культур. Рекомендації. М.: ФГНУ
Росінформагротех, 2002. 140 с.
. Рівні і тенденції зміни
видового складу і внутрипопуляционної структури, ареали комплексів шкідливих і
корисних організмів і прогноз небезпечних фітосанітарних ситуацій за зонами
країни. Ред. К.В. Новожилов, В.А. Захаренко. Санкт-Петербург, 2000. 100 с.
.Хасанов Б.А. Жовта плямистість
листя злаків, що викликається Pyrenophora tritici-repentis (Died.) Drechs. /
Мікологія і фітопатологія. 1988. Т. 22. Вип. 1. С. 78-83.
. Гранин Е.Ф. Пиренофороз
озимой пшеницы на Северном Кавказе / Е.Ф. Гранич, Э.М. Монастырская, Г.А.
Краева, К.Ю. Кочубей // Защита растений. - 1989. - № 2. - С. 21.
. Волкова Г.В. Динамика
основных возбудителей пятнистостей листьев озимой пшеницы в различных по
экоресурсам районах Северного Кавказа / Г.В. Волкова, А.Е. Андронова, О.Ю.
Кремнева // Междунар. научно-практ.
. Ciuffetti L.M., Tuori R.P.
Advances in the characterization of Pyrenophora tritici-repentis. wheat
interaction. / Phytopathology. V. 89. No 6. P. 444-449.
. Поспехов Г.В. Особливості
росту і плодоношення гриба Pyrenophora tritici-repentis (Died.) Drechs. в
культурі. / Мікологія і фітопатологія. 1989. Т. 23. Вип. 2. C. 117-121.